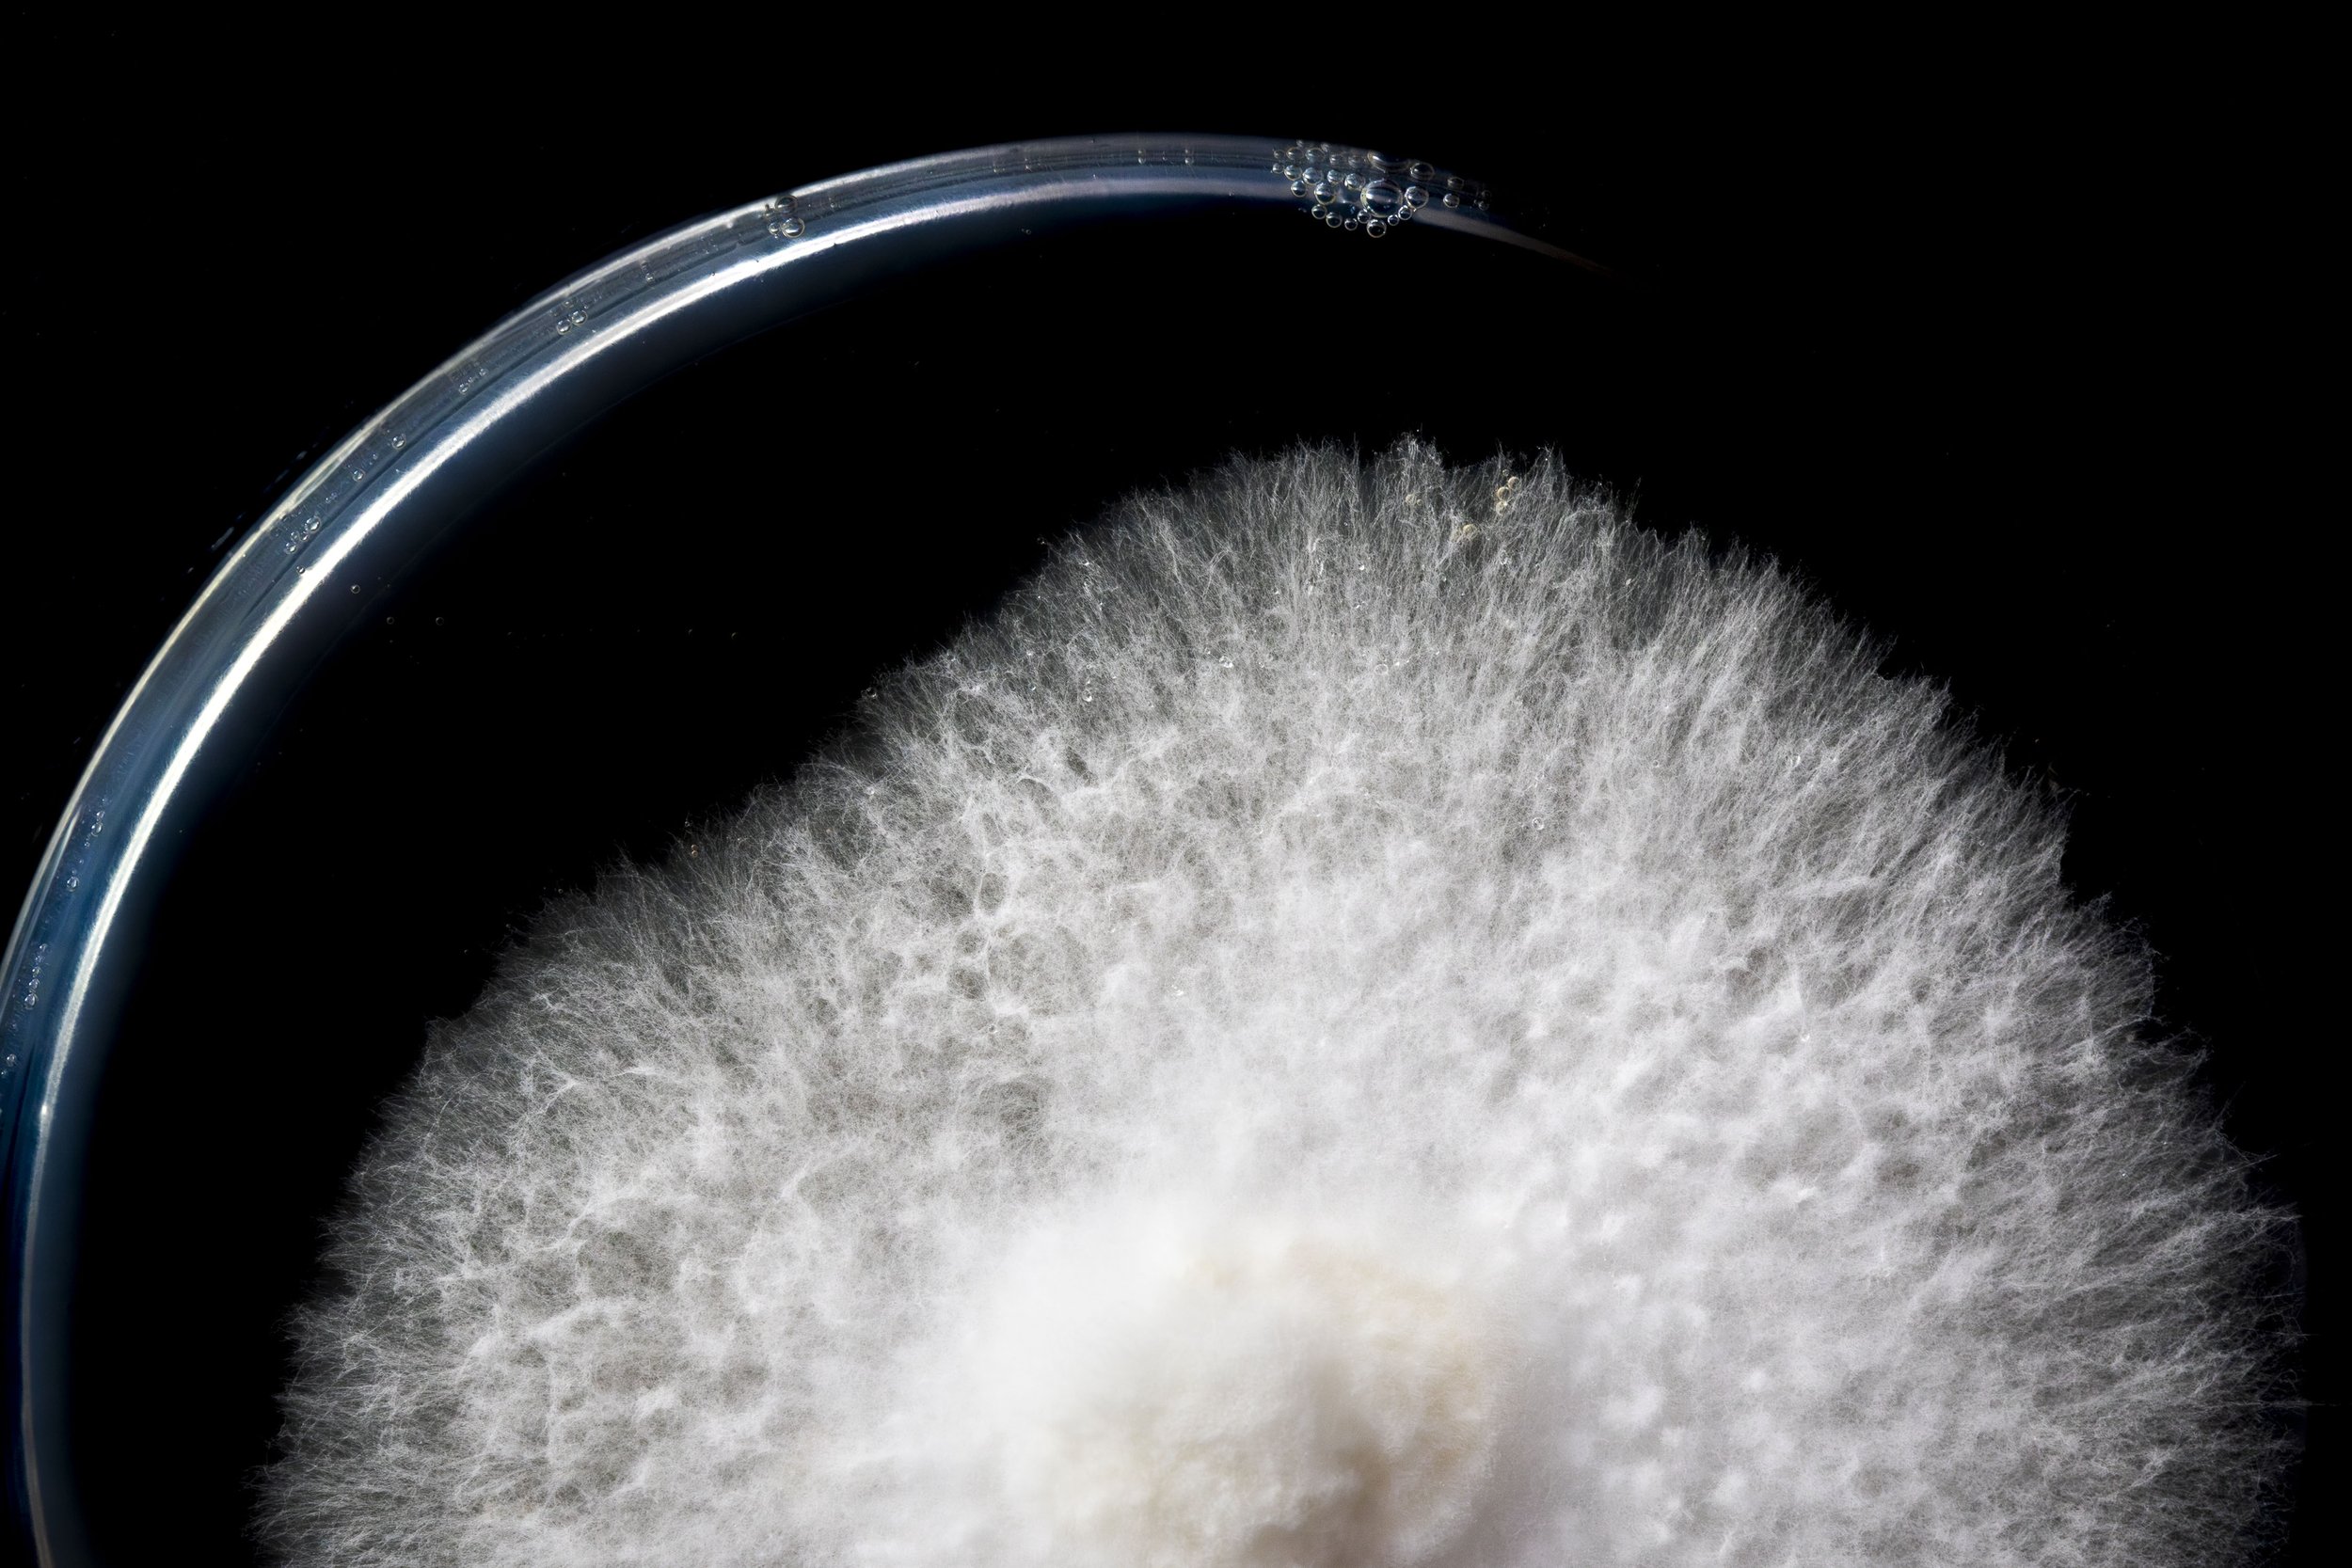
Mycelium in agar plate
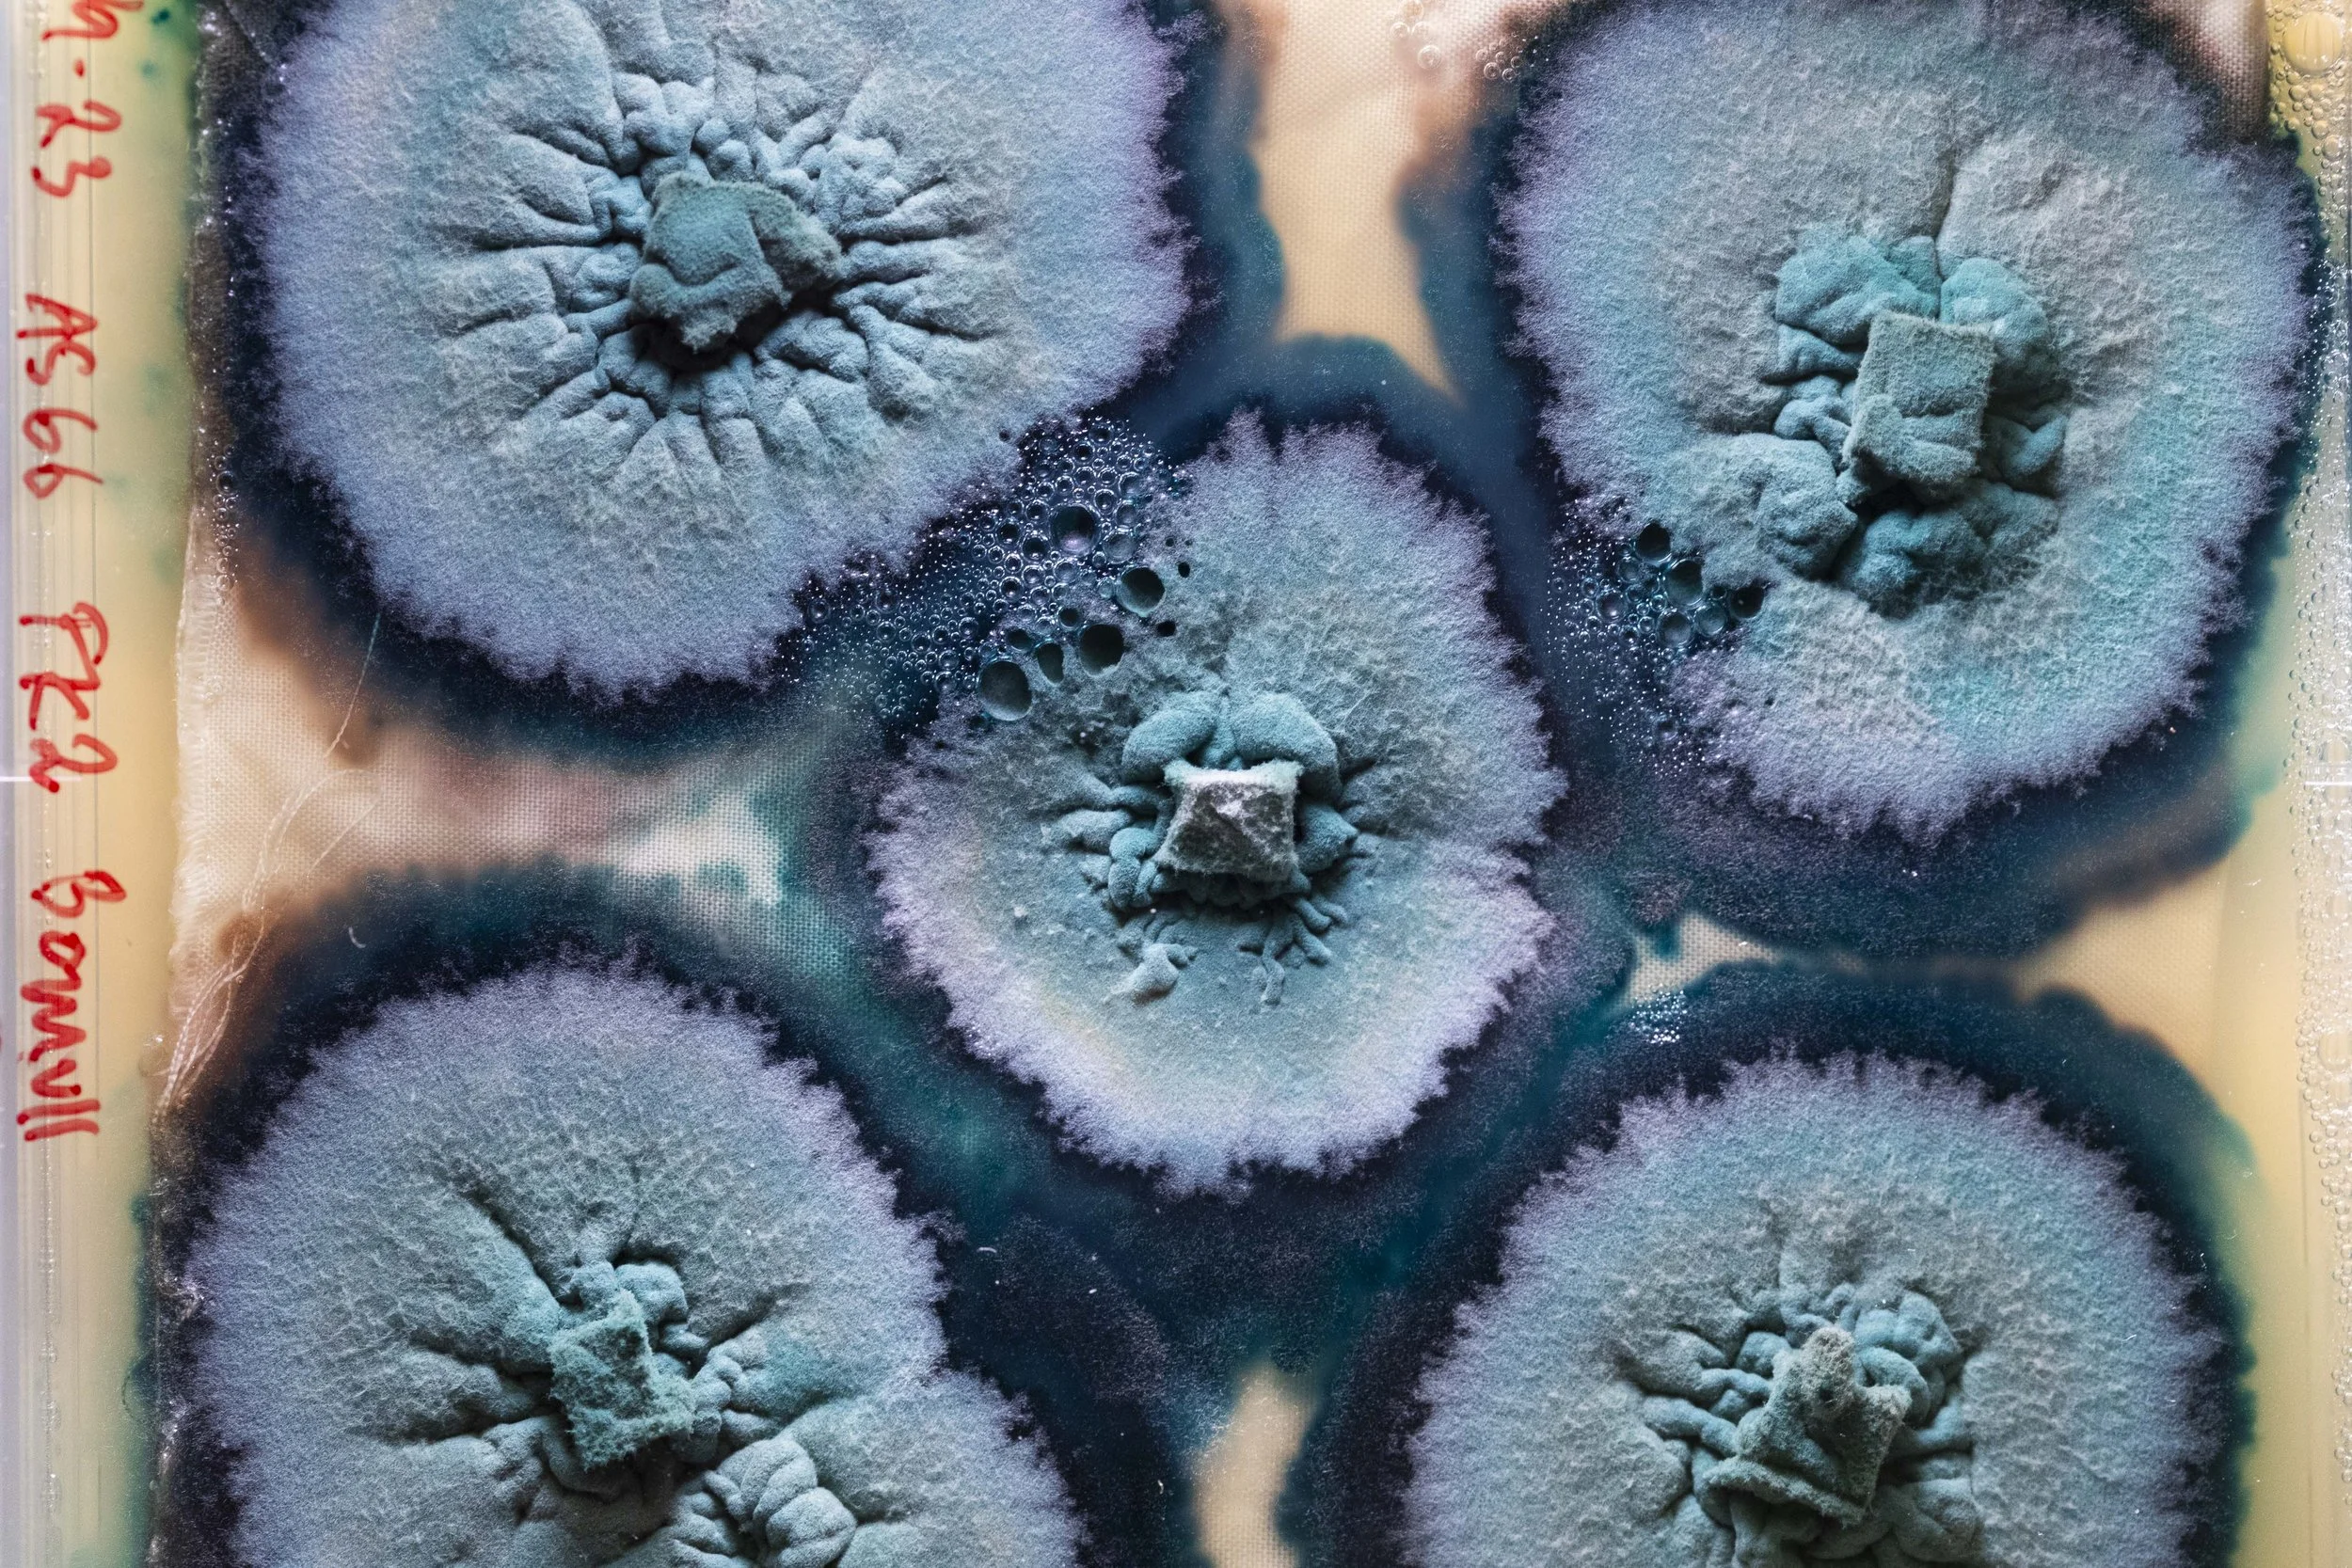
Fungi for colorant

Since the time of hunters and gatherers, humans have been collecting mushrooms for both food and medicine. However, it is only now, tens of thousands of years later, that we have discovered mushrooms' intrinsic properties and immense potential.
The mushroom you find in a risotto, on a moldy lemon, or growing on a dead tree in the forest is just a fraction of what fungi are and how they manifest. Both the scientific community and the general public are now starting to open their eyes to the possibilities of fungi, which hold promising solutions to a wide range of problems. This is thanks to the combination of fungi’s and humanity’s intelligence and versatility.
The golden age of fungi has begun. Hopefully, in the near future, we will see fungi as an indispensable partner in building a better world. Fungi as building materials, for breaking down hazardous environmental substances, in the food industry, dyes for textiles and in psychotherapy are methods now beginning to be implemented. The often destructive methods traditionally used in these fields are now being threatened by the sustainable and efficient fungi.Fungi have already saved us once with penicillin. Now, we are beginning to realize that was only the beginning of their problem-solving capabilities.
Different species of fungi

King Oyster Mushroom

Mycelium

Pillars made from sawdust and mycelium

Before and after purifying water with fungi

Mushrooms growing inside a mine

In the mines

Searching for small fungi species

Foodscientists
Mycelium in agar plate

Process of making meat substitute

Meat substitute

Non-toxic fungi colorant

Non-toxic fungi colorant on textile
Fungi for colorant

Psilocybin mushroom for therapy

Patient undergoing psychotherapy

Coral fungus

Reishi

Mushroom hunter